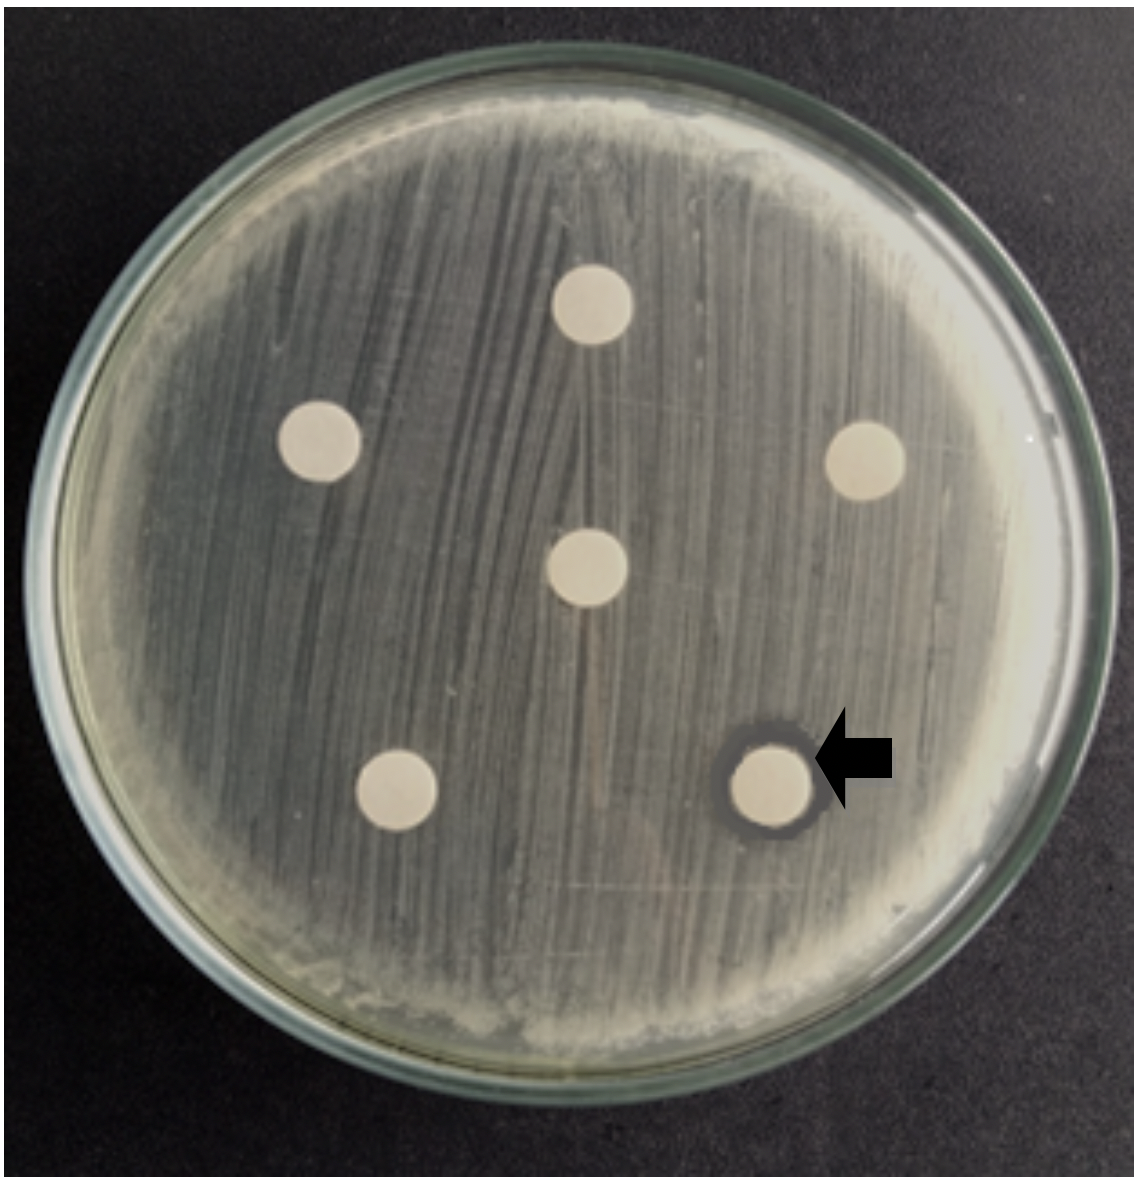

Philipp. Sci. Lett. 2019 12 (Supplement) 070-080
available online: July 17, 2019
*Corresponding author
Email Address: baldomerojohnrex@gmail.com
Date Received: February 15, 2019
Date Revised: June 22, 2019
Date Accepted: July 2, 2019
Biosorption of nickel by Bacillus cereus and Stenotrophomonas maltophilia isolated from Bayto River, Zambales
Heavy metal contamination of water systems is a global environmental concern and biosorption of these heavy metals by using bacteria offers a more potent and cost-effective solution compared to conventional methods. In this study 139 nickel-resistant isolates were obtained from the water samples collected from Bayto River, Santa Cruz, Zambales, Philippines. The metal-resistance profiles of the isolates were determined by using the Kirby-Bauer disc diffusion method. Found to tolerate the highest concentration of nickel tested, i.e., 10,000 ppm, were 16 isolates, and they were subjected to multimetal resistance assays. Out of the 16 most nickel-resistant isolates, 4 were able to tolerate 7,500 parts per million (ppm) copper, and 10,000 ppm chromium and lead. These isolates (S2Q1, S1I2, S3Z1, S2P1) were subjected to biosorption assay. Biosorption of nickel by these isolates was determined by inoculating 16-hour-nutrient broth (NB) cultures to NB supplemented with 1000 ppm nickel. The metal-microbe suspensions were incubated at room temperature in a rotary shaker at 150 rpm for 24 hours. Afterward, the NB from each setup was centrifuged, and the supernatants were analyzed by using atomic absorption spectrophotometry (AAS). The S1I2 exhibited the highest biosorption percentage at 92.27%, followed by S3Z1 (91.67%), S2Q1 (91.36%), and S2P1 (89.78%). The 4 isolates were identified via 16S rRNA sequencing. S1I2 and S2Q1 were identified as Stenotrophomonas maltophilia, while S3Z1 and S2P1 were identified as Bacillus cereus. These isolates can be utilized in the development of facilities for the treatment of contaminated waters.
© 2025 SciEnggJ
Philippine-American Academy of Science and Engineering